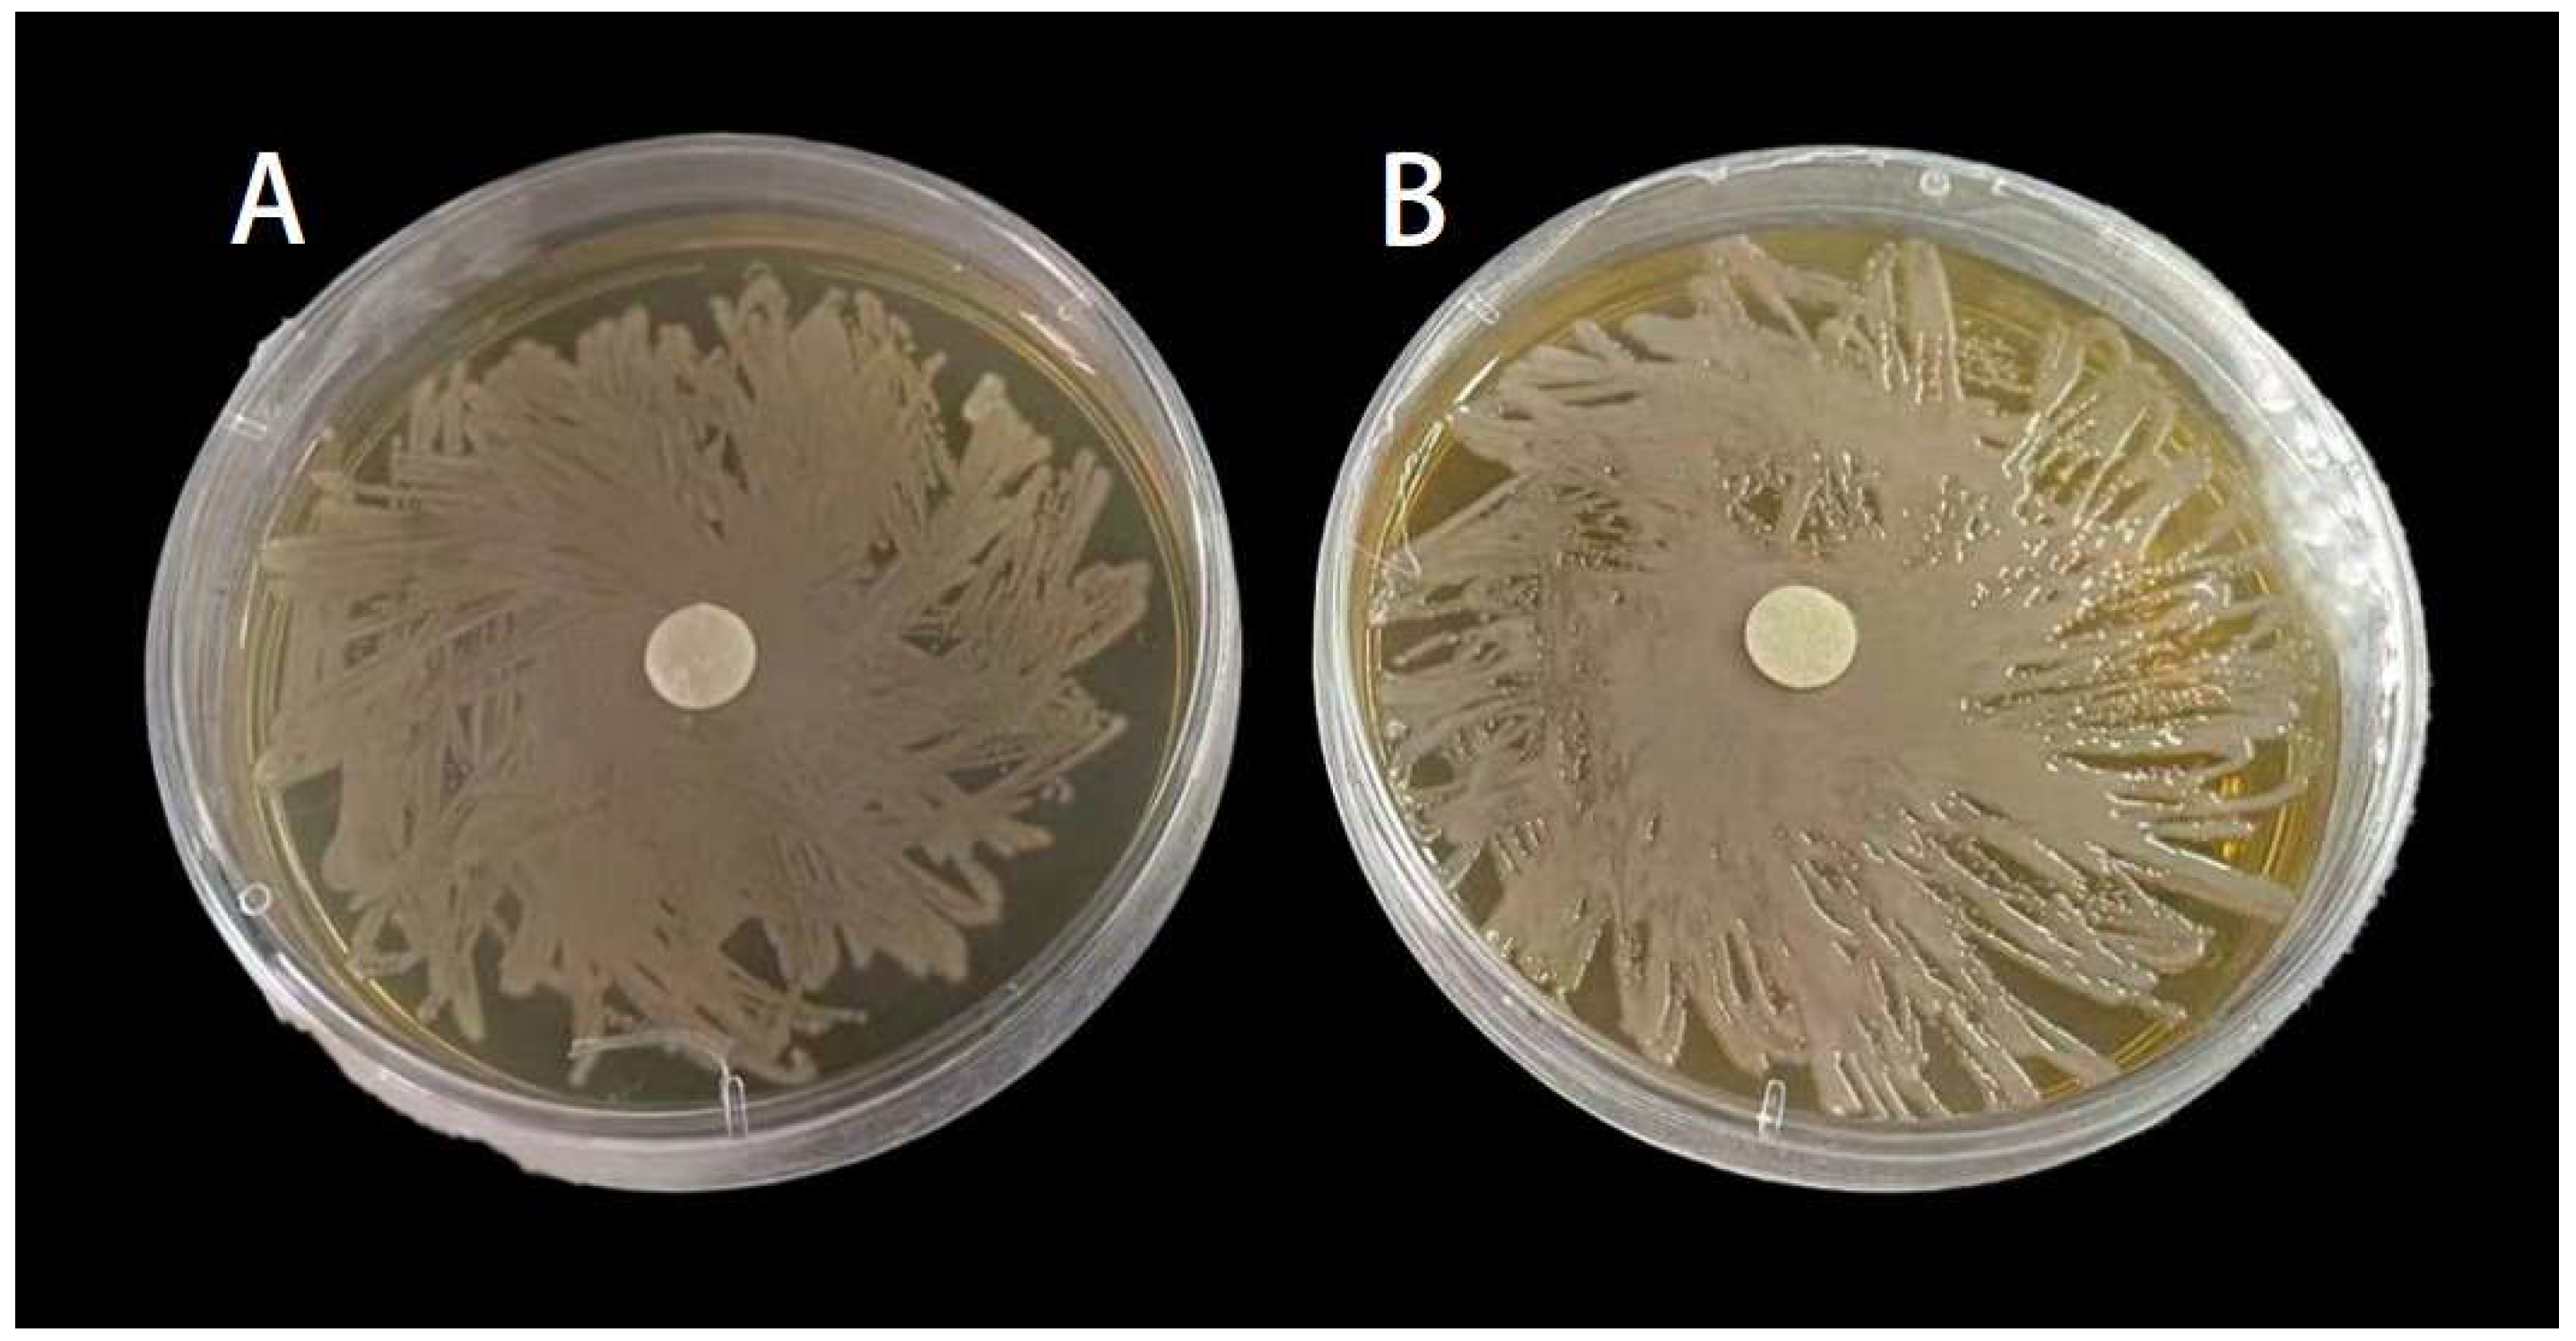
Insects 15 01019 g005
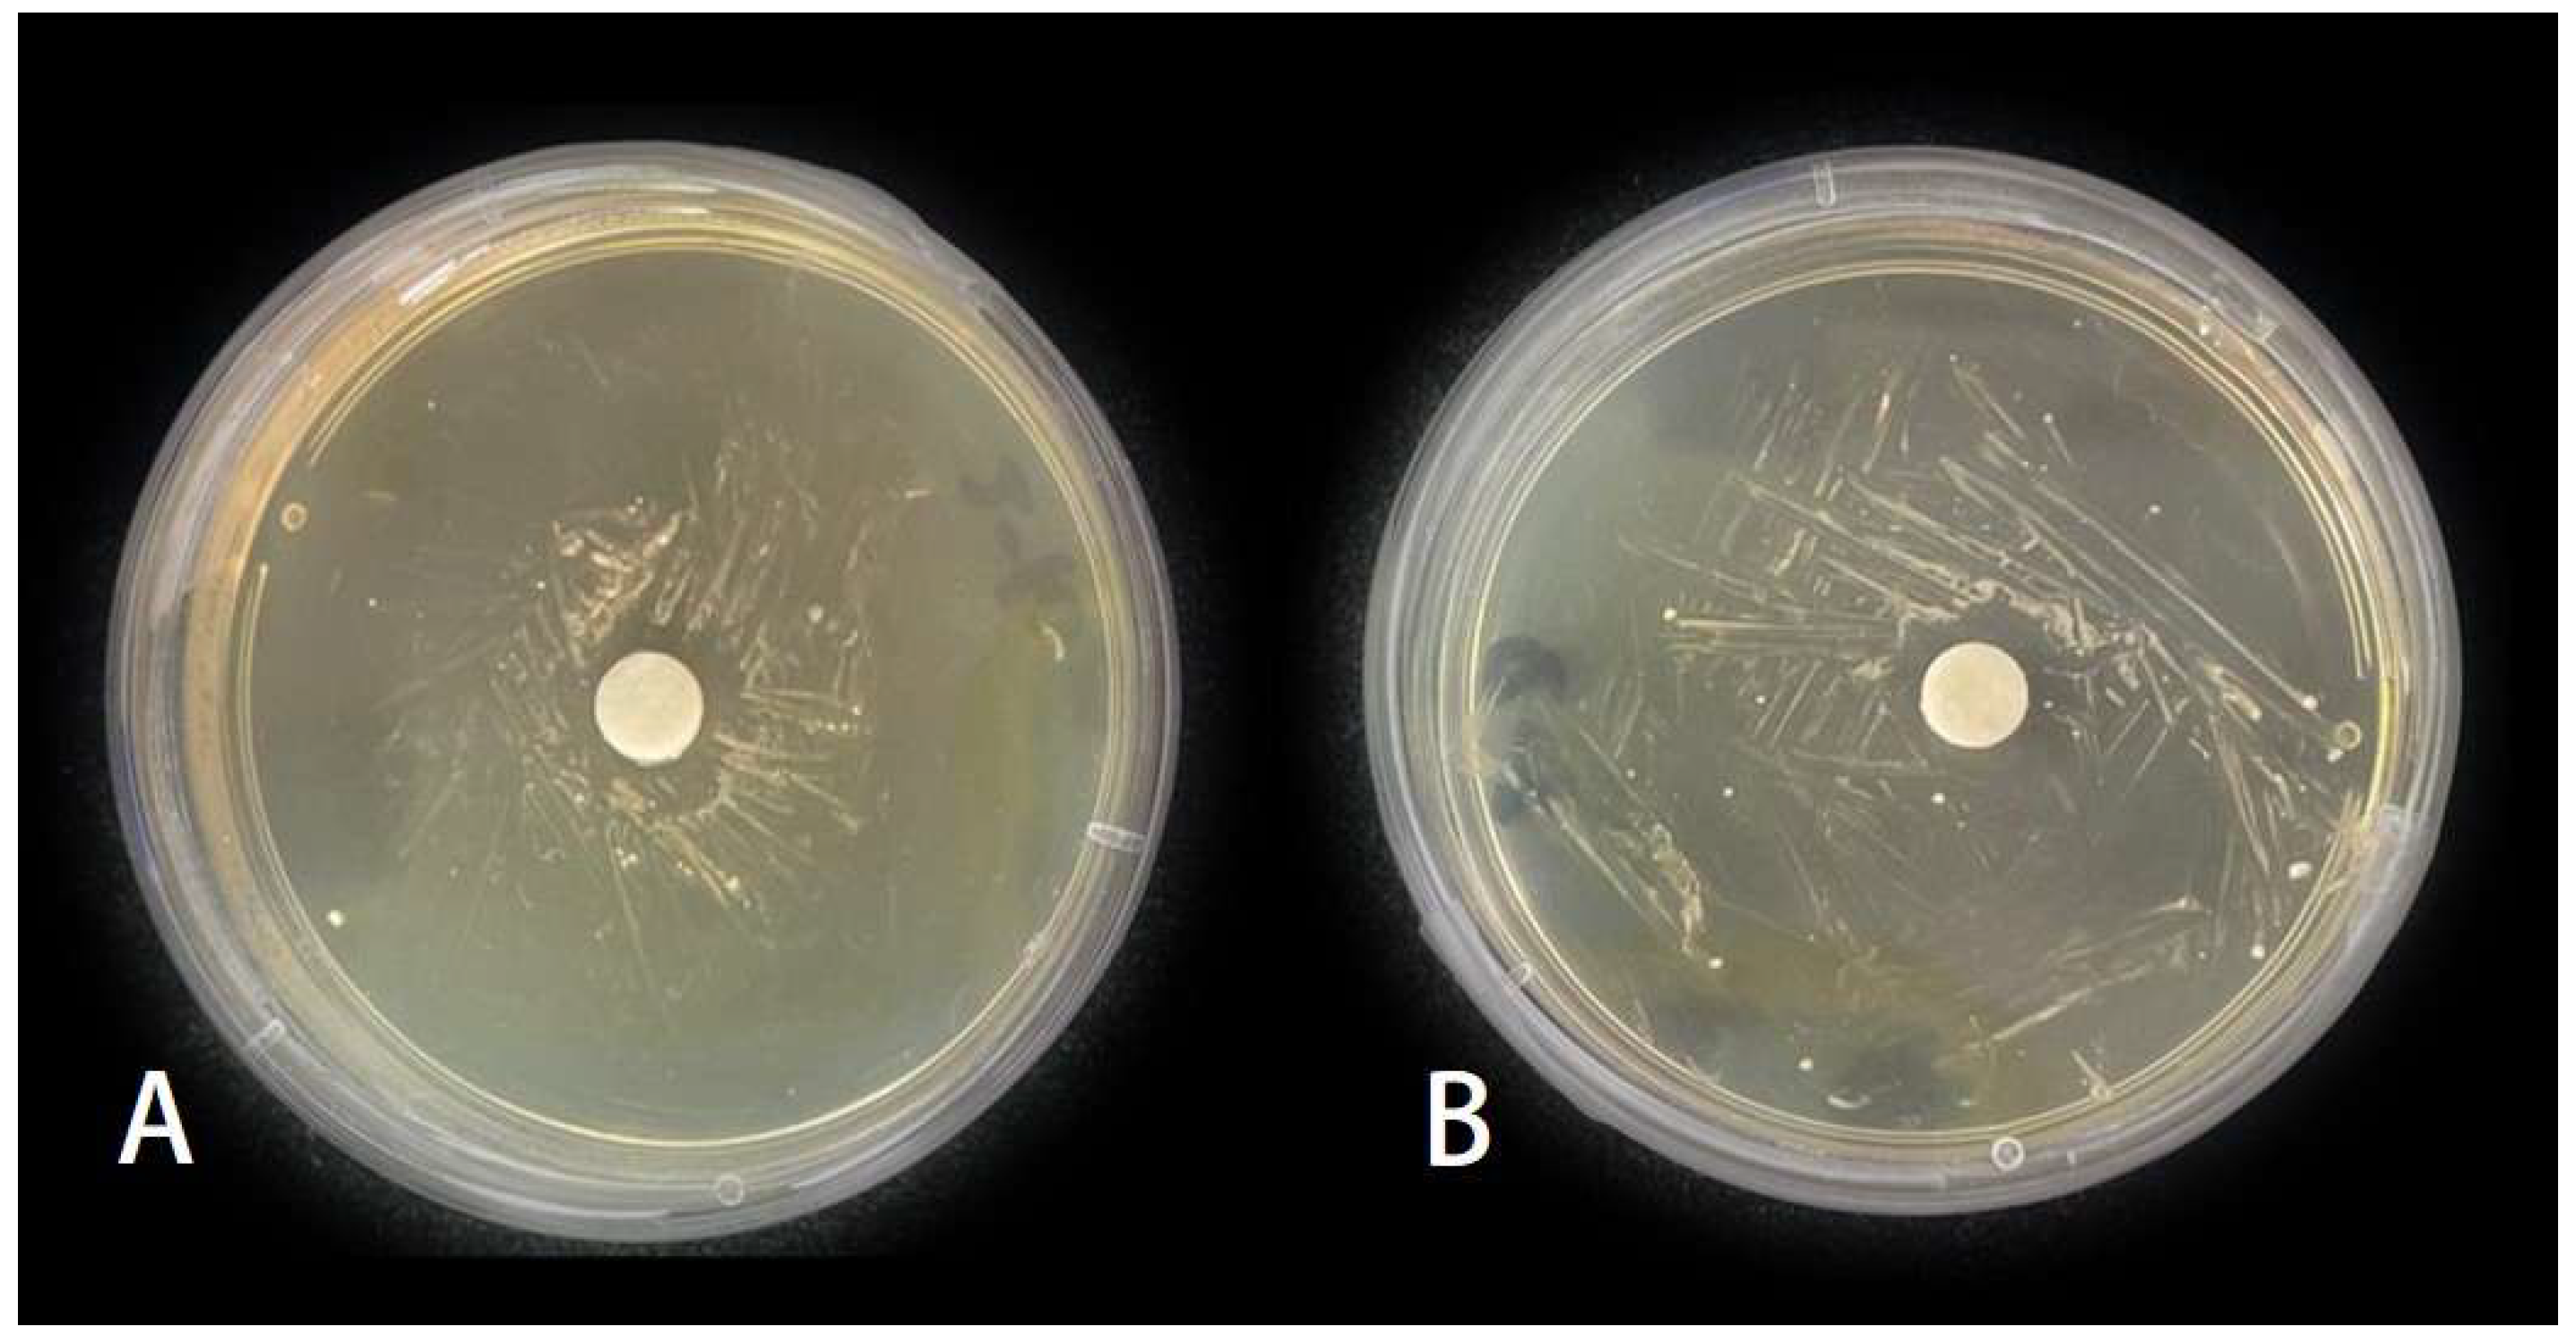
Insects 15 01019 g007

Antimicrobial Activity of Compounds Isolated from the Nest Material of Crematogaster rogenhoferi (Mayr) (Hymenoptera: Formicidae)
Simple Summary
Abstract
1. Introduction
2. Materials and Methods
2.1. Samples and Chemicals
2.2. The Extract Chemicals Analysis of C. rogenhoferi Nest Materials and Workers
2.3. Gas Chromatography-Mass Spectrometry (GC-MS)
2.4. Micro-Organisms Inhibition
2.5. Statistical Analysis
3. Results
3.1. Identification and Quantification of Chemicals Extracted from C. rogenhoferi Nests
3.2. Chemcial Extracts from Different Parts of Crematogaster Rogenhoferi Workers
3.3. Inhibitory Effect of MP and LP Against Serratia marcescens
3.4. Effect of MP and LP Against Beauveria bassiana
3.5. Effects of MP and LP on the Mycelium Extension of Beauveria bassiana Through Fumigation
4. Discussion
Author Contributions
Funding
Data Availability Statement
Conflicts of Interest
References
- Angelone, S.; Bidochka, M.J. Diversity and abundance of entomopathogenic fungi at ant colonies. J. Invertebr. Pathol. 2018, 156, 73–76. [Google Scholar] [CrossRef] [PubMed]
- Schmid-Hempel, P. Parasites in Social Insects; Princeton University Press: Princeton, NJ, USA, 1999; p. 392. ISBN 9780691059235. [Google Scholar]
- Cotter, S.C.; Kilner, R.M. Personal immunity versus social immunity. Behav. Ecol. 2010, 21, 663–668. [Google Scholar] [CrossRef]
- Cremer, S.; Armitage, S.A.O.; Schmid-Hempel, P. Social immunity. Curr. Biol. 2007, 17, R693–R702. [Google Scholar] [CrossRef] [PubMed]
- Obin, M.S.; Vander Meer, R.K. Gaster flagging by fire ants (Solenopsis spp.): Functional significance of venom dispersal behavior. J. Chem. Ecol. 1985, 11, 1757–1768. [Google Scholar] [CrossRef] [PubMed]
- Li, S.; Jin, X.; Chen, J. Effects of piperidine and piperideine alkaloids from the venom of red imported fire ants, Solenopsis invicta Buren, on Pythium ultimum Trow growth in vitro and the application of piperideine alkaloids to control cucumber damping-off in the greenhouse. Pest Manag. Sci. 2012, 68, 1546–1552. [Google Scholar] [CrossRef] [PubMed]
- Currie, C.R.; Scott, J.A.; Summerbell, R.C.; Malloch, D. Fungus-growing ants use antibiotic-producing bacteria to control garden parasites. Nature 1999, 398, 701–704. [Google Scholar] [CrossRef]
- Ratzka, C.; Förster, F.; Liang, C.; Kupper, M.; Dandekar, T.; Feldhaar, H.; Gross, R. Molecular characterization of antimicrobial peptide genes of the carpenter Ant Camponotus floridanus. PLoS ONE 2012, 7, e43036. [Google Scholar] [CrossRef]
- Frank, E.T.; Kesner, L.; Liberti, J.; Helleu, Q.; Leboeuf, A.C.; Dascalu, A.; Sponsler, D.B.; Azuma, F.; Economo, E.P.; Waridel, P.; et al. Targeted treatment of injured nestmates with antimicrobial compounds in an ant society. Nat. Commun. 2023, 14, 8446. [Google Scholar] [CrossRef] [PubMed]
- Pull, C.D.; Ugelvig, L.V.; Wiesenhofer, F.; Grasse, A.V.; Tragust, S.; Schmitt, T.; Brown, M.J.; Cremer, S.; Tautz, D. Destructive disinfection of infected brood prevents systemic disease spread in ant colonies. Elife 2018, 7, e32073. [Google Scholar] [CrossRef] [PubMed]
- Masson, F.; Brown, R.L.; Vizueta, J.; Irvine, T.; Xiong, Z.; Romiguier, J.; Stroeymeyt, N. Pathogen-specific social immunity is associated with erosion of individual immune function in an ant. Nat. Commun. 2024, 15, 9260. [Google Scholar] [CrossRef] [PubMed]
- Wang, L.; Elliott, B.; Jin, X.; Zeng, L.; Chen, J. Antimicrobial properties of nest volatiles in red imported fire ants, Solenopsis invicta (Hymenoptera: Formicidae). Sci. Nat. 2015, 102, 66. [Google Scholar] [CrossRef] [PubMed]
- Maschwitz, U.; Koob, K.; Schildknecht, H. Ein Beitrag zur Funktion der Metathoracaldrüse der Ameisen. J. Insect Physiol. 1970, 16, 387–404. [Google Scholar] [CrossRef]
- Ortius-Lechner, D.; Maile, R.; Morgan, E.D.; Boomsma, J.J. Metapleural gland secretion of the leaf-cutter ant Acromyrmex octospinosus: New compounds and their functional significance. J. Chem. Ecol. 2000, 26, 1667–1683. [Google Scholar] [CrossRef]
- Yek, S.H.; Mueller, U.G. The metapleural gland of ants. Biol. Rev. Camb. Philos. Soc. 2011, 86, 774–791. [Google Scholar] [CrossRef] [PubMed]
- Li, S.; Jiang, S.; Jia, W.; Guo, T.; Wang, F.; Li, J.; Yao, Z. Natural antimicrobials from plants: Recent advances and future prospects. Food Chem. 2024, 432, 137231. [Google Scholar] [CrossRef]
- Brütsch, T.; Jaffuel, G.; Vallat, A.; Turlings, T.C.J.; Chapuisat, M. Wood ants produce a potent antimicrobial agent by applying formic acid on tree-collected resin. Ecol. Evol. 2017, 7, 2249–2254. [Google Scholar] [CrossRef] [PubMed]
- Chapuisat, M.; Oppliger, A.; Magliano, P.; Christe, P. Wood ants use resin to protect themselves against pathogens. Proc. Biol. Sci. 2007, 274, 2013–2017. [Google Scholar] [CrossRef]
- Wu, Q.; Chen, Q.; Huang, W.; Wu, Y.; Tan, C.; Xu, X.; Li, S.; Zhang, Z. Study on extraction and antibacterial activity of long chain fat alcohol in honeycomb. J. Jiangsu Ocean. Univ. Nat. Sci. Ed. 2017, 26, 30–33. [Google Scholar] [CrossRef]
- Zhi, D.; Yang, T.; Liu, Q.; Peng, J.; Gong, X.; Dong, K. Biological activities of honeybee combor its extract. J. Bee 2021, 41, 9–11. [Google Scholar]
- Simone-Finstrom, M.; Spivak, M. Propolis and bee health: The natural history and significance of resin use by honey bees. Apidologie 2010, 41, 295–311. [Google Scholar] [CrossRef]
- Dirgantara, S.; Insanu, M.; Fidrianny, I. Medicinal properties of ant nest plant (Myrmecodia Genus): A comprehensive review. Open Access Maced. J. Med. Sci. 2022, 10, 97–103. [Google Scholar] [CrossRef]
- Lisnanti, E.; Lokapirnasari, W.; Pramyrtha, H.; Al, A.; Baihaqi, Z.; Yulianto, A. Antibacterial alternatives using the potential of the ant nest plant (Myrmecodia spp.). Int. J. One Health 2024, 10, 148–152. [Google Scholar] [CrossRef]
- Langshiang, E.S.; Hajong, S.R. Determination of structural features of the nest material of Crematogaster rogenhoferi (Mayr, 1879), (Hymenoptera: Myrmicinae). J. Entomol. Zool. Stud. 2018, 6, 1626–1631. [Google Scholar]
- Langshiang, E.S.; Hajong, S.R. Antifungal activity of isolates obtained from the nest material of Crematogaster rogenhoferi (Mayr, 1879) (Hymenoptera: Myrmicinae). J. Zool. Sci. 2018, 6, 1–6. [Google Scholar]
- Ning, D.; Yang, F.; Xiao, Q.; Ran, H.; Xu, Y. A simple and efficient method for preventing ant escape (Hymenoptera: Formicidae). Myrmecol. News 2019, 29, 57–65. [Google Scholar] [CrossRef]
- Traub, W.H. Antibiotic susceptibility of Serratia marcescens and Serratia liquefaciens. Chemotherapy 2000, 46, 315–321. [Google Scholar] [CrossRef]
- Moraes, A.; Videira, S.; Bittencourt, V.; Bittencourt, A. Antifungal activity of Stenotrophomonas maltophilia in Stomoxys calcitrans larvae. Rev. Bras. Parasitol. Vet. 2014, 23, 194–199. [Google Scholar] [CrossRef]
- Yang, A.H.; Yeh, K.W. Molecular cloning, recombinant gene expression, and antifungal activity of cystatin from taro (Colocasia esculenta cv. Kaosiung no. 1). Planta 2005, 221, 493–501. [Google Scholar] [CrossRef] [PubMed]
- Tugay, T.; Zhdanova, N.; Zheltonozhsky, V.; Sadovnikov, L.; Dighton, J. The influence of ionizing radiation on spore germination and emergent hyphal growth response reactions of microfungi. Mycologia 2006, 98, 521–527. [Google Scholar] [CrossRef]
- Diez, L.; Urbain, L.; Lejeune, P.; Detrain, C. Emergency measures: Adaptive response to pathogen intrusion in the ant nest. Behav. Process. 2015, 116, 80–86. [Google Scholar] [CrossRef]
- Li, X.; Chen, L.; Fang, S. Analysis of alkaloid components in the soil from the nest of the red imported fire ant, Solenopsis invicta (Hymenoptera: Formicidae). Acta Entomol. Sin. 2020, 63, 494–501. [Google Scholar] [CrossRef]
- Li, S.; Jin, X.; Chen, J.; Lu, S. Inhibitory activities of venom alkaloids of red imported fire ant against Clavibacter michiganensis subsp. michiganensis in vitro and the application of piperidine alkaloids to manage symptom development of bacterial canker on tomato in the greenhouse. Int. J. Pest Manag. 2013, 59, 150–156. [Google Scholar] [CrossRef]
- Chen, J.; Henderson, G.; Grimm, C.C.; Lloyd, S.W.; Laine, R.A. Termites fumigate their nests with naphthalene. Nature 1998, 392, 558–559. [Google Scholar] [CrossRef]
- Rosengaus, R.B.; Guldin, M.R.; Traniello, J.F.A. Inhibitory effect of termite fecal pellets on fungal spore germination. J. Chem. Ecol. 1998, 24, 1697–1706. [Google Scholar] [CrossRef]
- Billen, J. Diversity and morphology of exocrine glands in ants. In Proceedings of the Annals XIX Symposium of Myrmecology, Ouro Preto, Brasil, 17–21 November 2009; pp. 1–6. [Google Scholar]
- Do Amaral, J.B.; Machado-Santelli, G.M. Salivary system in leaf-cutting ants (Atta sexdens rubropilosa Forel, 1908) castes: A confocal study. Micron 2008, 39, 1222–1227. [Google Scholar] [CrossRef]
- Chen, J. Qualitative analysis of red imported fire ant nests constructed in silica gel. J. Chem. Ecol. 2007, 33, 631–642. [Google Scholar] [CrossRef] [PubMed]
- Turillazzi, S.; Mastrobuoni, G.; Dani, F.R.; Moneti, G.; Pieraccini, G.; la Marca, G.; Bartolucci, G.; Perito, B.; Lambardi, D.; Cavallini, V. Dominulin A and B: Two new antibacterial peptides identified on the cuticle and in the venom of the social paper wasp Polistes dominulus using MALDI-TOF, MALDI-TOF/TOF, and ESI-ion Trap. J. Am. Soc. Mass Spectrom. 2006, 17, 376–383. [Google Scholar] [CrossRef] [PubMed]
- Hart, B.L. The evolution of herbal medicine: Behavioural perspectives. Anim. Behav. 2005, 70, 975–989. [Google Scholar] [CrossRef]
- Amarowicz, R.; Dykes, G.A.; Pegg, R.B. Antibacterial activity of tannin constituents from Phaseolus vulgaris, Fagoypyrum esculentum, Corylus avellana and Juglans nigra. Fitoterapia 2008, 79, 217–219. [Google Scholar] [CrossRef]
- Dinda, B.; Debnath, S.; Mohanta, B.; Harigaya, Y. Naturally occurring triterpenoid saponins. Chem. Biodivers. 2010, 7, 2327–2580. [Google Scholar] [CrossRef]
- Al Manar, P.; Ekaputra Utama, S.; Hasan, G.; Hidayat, S. Review: The potential of sarang semut (Myrmecodia spp.) as medicinal plants. IOP Conf. Ser. Earth Environ. Sci. 2019, 394, 12032. [Google Scholar] [CrossRef]
- Yuan, G.; Guan, Y.; Yi, H.; Lai, S.; Sun, Y.; Cao, S. Antibacterial activity and mechanism of plant flavonoids to gram-positive bacteria predicted from their lipophilicities. Sci. Rep. 2021, 11, 10471. [Google Scholar] [CrossRef]
- Bae, J.; Seo, Y.; Oh, S. Antibacterial activities of polyphenols against foodborne pathogens and their application as antibacterial agents. Food Sci. Biotechnol. 2022, 31, 985–997. [Google Scholar] [CrossRef]
- Rodrigues Da Silva, M.; Sanchez Bragagnolo, F.; Lajarim Carneiro, R.; de Oliveira Carvalho Pereira, I.; Aquino Ribeiro, J.A.; Martins Rodrigues, C.; Jelley, R.E.; Fedrizzi, B.; Soleo Funari, C. Metabolite characterization of fifteen by-products of the coffee production chain: From farm to factory. Food Chem. 2022, 369, 130753. [Google Scholar] [CrossRef] [PubMed]
- Singh, P.; Ranjan, R.; Tripathi, R.; Dixit, J.; Sinha, N.; Singh, A.K.; Tiwari, K.N. GC-MS and NMR spectroscopy based metabolite profiling of Panchvalkal kwath (polyherbal formulation). Nat. Prod. Res. 2023, 37, 1221–1226. [Google Scholar] [CrossRef] [PubMed]
- Villareal, M.; Han, J.; Matsuyama, K.; Sekii, Y.; Smaoui, A.; Isoda, H. Lupenone from Erica multiflora leaf extract stimulates melanogenesis in B16 murine melanoma cells through the inhibition of ERK1/2 activation. Planta Med. 2013, 79, 236–243. [Google Scholar] [CrossRef]
- Malik, W.; Ahmed, D.; Izhar, S. Tyrosinase inhibitory activities of Carissa opaca Stapf ex Haines roots extracts and their phytochemical analysis. Pharmacogn. Mag. 2017, 13, S544–S548. [Google Scholar] [CrossRef]
- Farooqi, S.S.; Naveed, S.; Qamar, F.; Sana, A.; Farooqi, S.H.; Sabir, N.; Mansoor, A.; Sadia, H. Phytochemical analysis, GC-MS characterization and antioxidant activity of Hordeum vulgare seed extracts. Heliyon 2024, 10, e27297. [Google Scholar] [CrossRef] [PubMed]
- Mihara, R.; Barry, K.M.; Mohammed, C.L.; Mitsunaga, T. Comparison of antifungal and antioxidant activities of Acacia mangium and A. auriculiformis heartwood extracts. J. Chem. Ecol. 2005, 31, 789–804. [Google Scholar] [CrossRef] [PubMed]
- Chew, Y.L.; Ling Chan, E.W.; Tan, P.L.; Lim, Y.Y.; Stanslas, J.; Goh, J.K. Assessment of phytochemical content, polyphenolic composition, antioxidant and antibacterial activities of Leguminosae medicinal plants in Peninsular Malaysia. BMC Complement. Altern. Med. 2011, 11, 12. [Google Scholar] [CrossRef] [PubMed]
- Perriot, R.; Breme, K.; Meierhenrich, U.J.; Carenini, E.; Ferrando, G.; Baldovini, N. Chemical composition of French mimosa absolute oil. J. Agric. Food. Chem. 2010, 58, 1844–1849. [Google Scholar] [CrossRef]
- Mutai, C.; Abatis, D.; Vagias, C.; Moreau, D.; Roussakis, C.; Roussis, V. Cytotoxic lupane-type triterpenoids from Acacia mellifera. Phytochemistry 2004, 65, 1159–1164. [Google Scholar] [CrossRef] [PubMed]
- Do Nascimento, R.R.; Jackson, B.D.; Morgan, E.D.; Clark, W.H.; Blom, P.E. Chemical secretions of two sympatric harvester ants, Pogonomyrmex salinus and Messor lobognathus. J. Chem. Ecol. 1993, 19, 1993–2005. [Google Scholar] [CrossRef]
- Guédot, C.; Millar, J.G.; Horton, D.R.; Landolt, P.J. Identification of a sex attractant pheromone for male winterform pear psylla, Cacopsylla pyricola. J. Chem. Ecol. 2009, 35, 1437–1447. [Google Scholar] [CrossRef] [PubMed]
- Kroiss, J.; Schmitt, T.; Schreier, P.; Strohm, E.; Herzner, G. A selfish function of a “social” gland? A postpharyngeal gland functions as a sex pheromone reservoir in males of the solitary wasp Philanthus triangulum. J. Chem. Ecol. 2006, 32, 2763–2776. [Google Scholar] [CrossRef] [PubMed]
- Hangartner, W.; Reichson, J.M.; Wilson, E.O. Orientation to nest material by the ant, Pogonomyrmex badius (Latreille). Anim. Behav. 1970, 18, 331–334. [Google Scholar] [CrossRef]
- Hubbard, M.D. Influence of nest material and colony odor on digging in the ant Solenopsis invicta (Hymenoptera: Formicidae). J. Ga. Entomol. Soc. 1974, 9, 127–132. [Google Scholar]
- Singer, T.L.; Espelie, K.E. Nest and nestmate recognition by a fungus-growing ant, Apterostigma collare Emery (Hymenoptera: Formicidae). Ethology 1998, 104, 929–939. [Google Scholar] [CrossRef]

| Peak No. | RT (min) | Molecular Formula | Compound | Relative Content% |
|---|---|---|---|---|
| 1 | 10.87 | 240.46 | 5,5-dibutylnonane | 4.67 |
| 2 | 11.63 | 240.47 | hexadecane, 3-methyl- | 3.37 |
| 3 | 15.14 | 254.49 | octadecane | 3.18 |
| 4 | 16.47 | 224.43 | cyclohexadecane | 1.50 |
| 5 | 19.66 | 340.50 | 2,2′-methylenebis[6-(1,1-dimethylethyl)-4-methyl-phenol] | 5.65 |
| 6 | 20.32 | 350.66 | 1-pentacosene | 7.81 |
| 7 | 20.65 | 352.68 | pentacosane | 4.05 |
| 8 | 21.08 | 366.71 | 11-methylpentacosane | 9.49 |
| 9 | 21.54 | 352.00 | 2-methyltetracosane | 5.35 |
| 10 | 23.36 | 394.76 | 13-methylheptacosane | 16.91 |
| 11 | 30.23 | 424.70 | lup-20(29)-en-3-one | 38.01 |
| Peak No. | RT (min) | Molecular Formula | Compound | Relative Content% |
|---|---|---|---|---|
| 1 | 4.28 | 240.28 | heptadecane | 6.04 |
| 2 | 4.48 | 206.17 | 2,4-di-tert-butylphenol | 8.57 |
| 3 | 14.33 | 296.34 | heneicosane | 3.98 |
| 4 | 15.07 | 310.36 | docosane | 5.17 |
| 5 | 19.60 | 340.50 | 2,2′-methylenebis[6-(1,1-dimethylethyl)-4-methyl-phenol] | 0.56 |
| 6 | 20.26 | 350.66 | 1-pentacosene | 8.87 |
| 7 | 20.59 | 352.68 | pentacosane | 9.25 |
| 8 | 21.04 | 366.71 | 9-methyl-nonadecane | 12.80 |
| 9 | 21.48 | 352.40 | 2-methyltetracosane | 5.18 |
| 10 | 22.95 | 380.34 | heptacosane | 14.48 |
| 11 | 23.29 | 394.76 | 13-methylheptacosane | 23.80 |
| Peak No. | RT (min) | Molecular Formula | Compound | Relative Content% |
|---|---|---|---|---|
| 1 | 3.17 | 198.235 | tetradecane | 6.88 |
| 2 | 3.50 | 212.250 | pentadecane | 37.71 |
| 3 | 3.90 | 226.266 | hexadecane | 5.67 |
| 4 | 5.90 | 268.313 | nonadecane | 12.69 |
| 5 | 9.10 | 352.407 | 9-octyl-heptadecane | 12.04 |
| 6 | 18.76 | 338.391 | tetracosane | 6.00 |
| 7 | 21.14 | 366.423 | hexacosane | 8.12 |
| Peak No. | RT (min) | Molecular Formula | Compound | Relative Content% |
|---|---|---|---|---|
| 1 | 19.60 | 340.50 | 2,2′-methylenebis[6-(1,1-dimethylethyl)-4-methyl-phenol] | 2.47 |
| 2 | 21.34 | 302.49 | (Z)-3-(pentadec-8-en-1-yl)phenol | 31.31 |
| 3 | 21.65 | 330.00 | (Z)-3-(Heptadec-10-en-1-yl)phenol | 30.40 |
| 4 | 22.18 | 328.53 | 3-((4Z,7Z)-Heptadeca-4,7-dien-1-yl) phenol | 2.23 |
| 5 | 23.50 | 358.33 | 3-(10Z)-10-nonadecen-1-yl-phenol | 6.07 |
| 6 | 23.79 | 304.51 | 3-pentadecyl-phenol | 2.05 |
| 7 | 24.90 | 208.26 | 5-methyl-2-(4-pyridyl)-Indole | 25.47 |
Disclaimer/Publisher’s Note: The statements, opinions and data contained in all publications are solely those of the individual author(s) and contributor(s) and not of MDPI and/or the editor(s). MDPI and/or the editor(s) disclaim responsibility for any injury to people or property resulting from any ideas, methods, instructions or products referred to in the content. |
© 2024 by the authors. Licensee MDPI, Basel, Switzerland. This article is an open access article distributed under the terms and conditions of the Creative Commons Attribution (CC BY) license (https://creativecommons.org/licenses/by/4.0/).
Share and Cite
Bai, W.; Chen, B.; Chen, H.; Nie, L.; Liang, M.; Xu, Y.; Lu, Y.; Wang, L. Antimicrobial Activity of Compounds Isolated from the Nest Material of Crematogaster rogenhoferi (Mayr) (Hymenoptera: Formicidae). Insects 2024, 15, 1019. https://doi.org/10.3390/insects15121019
Bai W, Chen B, Chen H, Nie L, Liang M, Xu Y, Lu Y, Wang L. Antimicrobial Activity of Compounds Isolated from the Nest Material of Crematogaster rogenhoferi (Mayr) (Hymenoptera: Formicidae). Insects. 2024; 15(12):1019. https://doi.org/10.3390/insects15121019
Chicago/Turabian StyleBai, Weihui, Baihe Chen, Huimei Chen, Lei Nie, Mingrong Liang, Yijuan Xu, Yongyue Lu, and Lei Wang. 2024. "Antimicrobial Activity of Compounds Isolated from the Nest Material of Crematogaster rogenhoferi (Mayr) (Hymenoptera: Formicidae)" Insects 15, no. 12: 1019. https://doi.org/10.3390/insects15121019
APA StyleBai, W., Chen, B., Chen, H., Nie, L., Liang, M., Xu, Y., Lu, Y., & Wang, L. (2024). Antimicrobial Activity of Compounds Isolated from the Nest Material of Crematogaster rogenhoferi (Mayr) (Hymenoptera: Formicidae). Insects, 15(12), 1019. https://doi.org/10.3390/insects15121019







